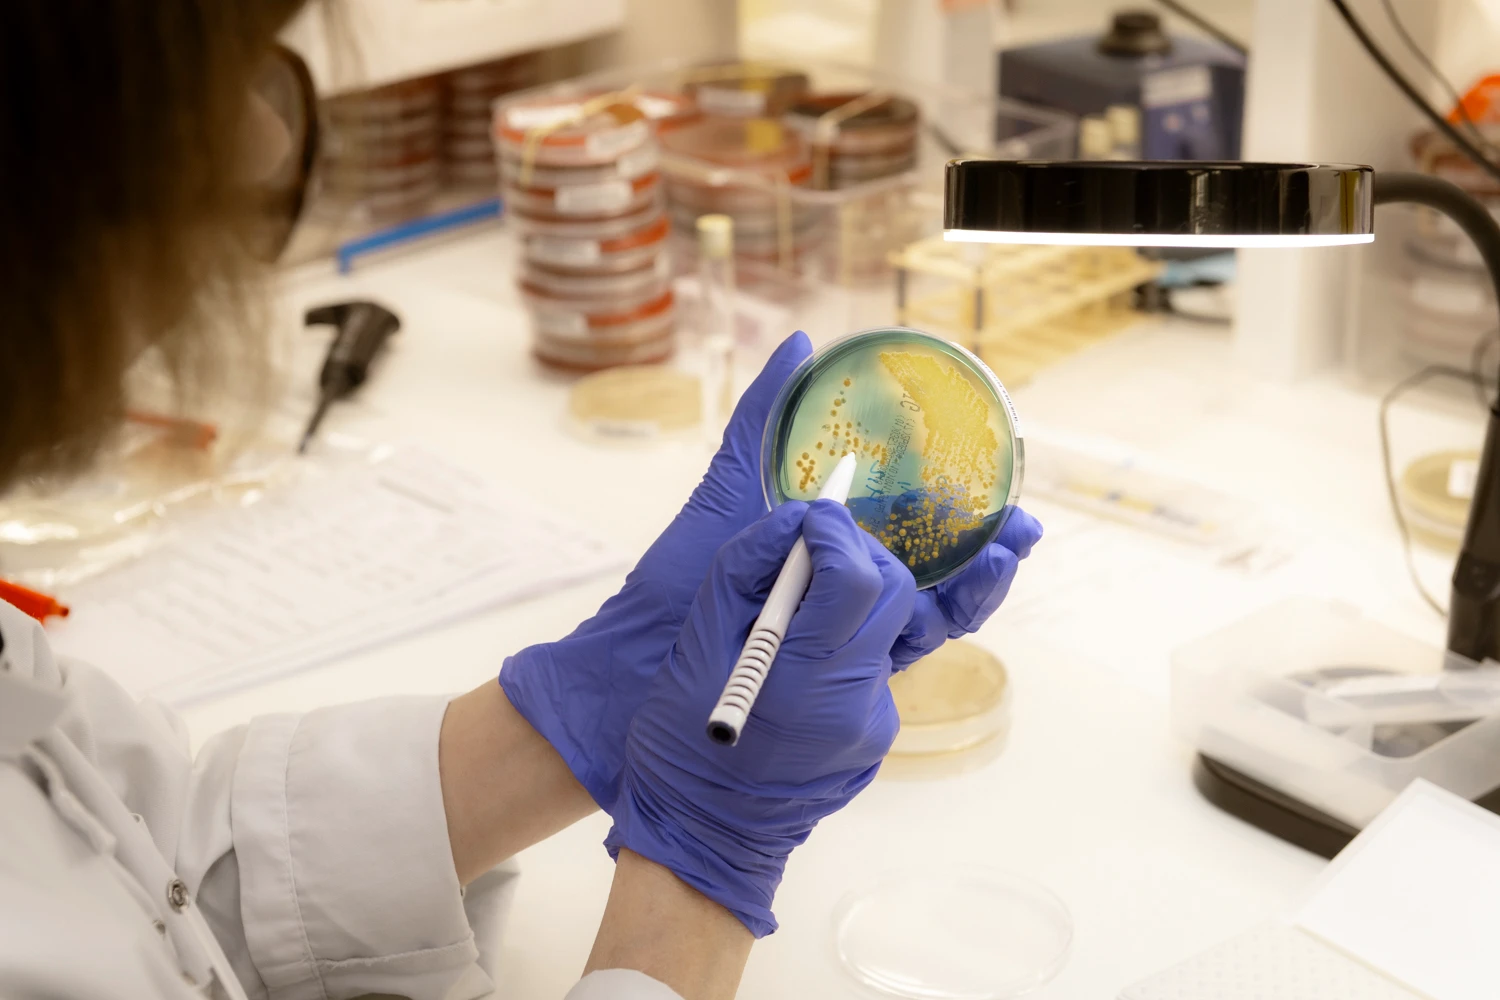

Nos actualités
En ce 28 mars, la Journée mondiale d’action pour la
« Ces cellules tueuses ont guéri leur cancer », la
L’unité AGIR de l’hôpital Raymond-Poincaré AP-HP, spécialisée dans la fabrication
La médecine connaît une accélération sans précédent. Pour que l’innovation
Le saviez-vous ? Votre Impôt sur la Fortune Immobilière peut
Et si une application 3D, une séance de cinéma ou
Le mandat des membres du Conseil scientifique de la Fondation
Le projet Starting Bloc, lauréat du dispositif Coup de Pouce
En 2025, la Fondation de l’AP-HP a choisi de soutenir
Et si péridurale ne rimait plus avec immobilité ? C’est
Les Médicaments de Thérapie Innovante (MTI) représentent une avancée scientifique
Pour les praticiens de l’AP-HP, la mobilité internationale ne se
L'oncologie interventionnelle entre dans une nouvelle dimension à l'AP-HP avec
La médecine du futur n’a jamais été aussi proche de
La Fondation de l’AP-HP lance la 4ème édition de ses
La Fondation de l’AP-HP ouvre la seconde édition de son
Et si l’expérience vécue de la maladie devenait une source
Comment donner du sens à son patrimoine tout en soutenant
Le 17 mars 2026, l’hôpital Bretonneau (AP-HP) a transformé ses
La période périnatale est une phase aux enjeux majeurs pour
Lauréat des « Coups de pouce 2025 » et projet
Sous-représentation dans les études cliniques, reconnaissance insuffisante des pathologies spécifiques
L’accès aux produits d'hygiène et dermo-cosmétiques reste un défi pour
La Fondation de l’AP-HP lance un appel à projets inédit